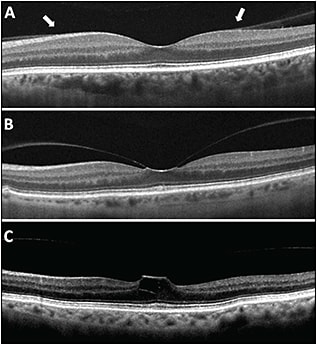

Patient Selection for Ocriplasmin Treatment of Patients With VMT
The honeymoon is over, but the marriage is stable.
WILLIAM E. SMIDDY, MD
Very few topics in the treatment of ophthalmic diseases have merited their being introduced in the New England Journal of Medicine. Ocriplasmin is a member of that elite group.1 It is a novel and potentially powerful agent of change for a condition that is more common than we recognized before the era of optical coherence tomography imaging.
However, now more than two years after its introduction, its novelty worn off, the question of where ocriplasmin fits into our therapeutic armamentarium has been more soberly asked.
The entity of vitreomacular traction (VMT) has been defined as vitreoretinal attachment within 6 mm of the fovea, surrounded by separated posterior cortical vitreous, in association with 20/25 visual acuity or worse.1 There may or may not be an associated full-thickness macular hole.
Optical coherence tomography is the means by which the diagnosis is defined,2 but OCT has also demonstrated the broad diagnostic spectrum3 and high prevalence of vitreomacular adhesion (VMA), showing us that VMT cases are only a small subset of cases with VMA (Figure).
Figure. OCT scans demonstrating VMA and VMT: A) Broad VMA with attachment >1,500 µm and no detectable change in foveal contour. B) Focal VMT with attachment ≤1,500 µm and distortion of the foveal surface. C) Focal VMT with foveal cystic changes.
Among this group, only some cases actually cause visual loss, much less symptomatic visual loss. It is that small subset (VMT) that was the subject of the pivotal trials of ocriplasmin (Jetrea, ThromboGenics, Iselin, NJ).
While this definition has served to standardize the entity of VMT, there is still incomplete knowledge about the natural history of VMT. This ambiguity was and remains a limitation when deciding when vitrectomy is indicated, and it is just as relevant to decisions regarding the use of ocriplasmin.
The purpose of this article is to discuss data and suggest guidelines for optimal use of ocriplasmin in contemporary vitreoretinal therapeutics. Its development (a long and interesting story that demonstrates the real-world difficulties of translational research), biochemistry, and potential applications to conditions other than VMT (such as diabetic macular edema and macular degeneration) are beyond the scope of this article.
William E. Smiddy, MD, is professor of ophthalmology at the Bascom Palmer Eye Institute of the University of Miami in Florida. He reports no financial interests in products mentioned in this article. Dr. Smiddy can be reached via e-mail at wsmiddy@umail.miami.edu.
NATURAL HISTORY PERSPECTIVES
A fundamental step is to define properly the condition being studied. That VMA represents an anomalous or incomplete posterior vitreous detachment has been recognized for many years.4 Indeed, only the most obvious cases could be appreciated clinically before the advent of OCT imaging, and they were commonly termed VMT syndrome.5
Clearly, OCT has allowed for more precise characterization, and the definition cited above1 will govern this review of the data as there is much overlap, extension to other entities, and not a little confusion in the application of VMT throughout the literature.6
Even among the more severe, clinically evident cases of VMA, it has been long recognized that spontaneous resolution can occur, but the earliest studies suggested frequencies of only approximately 10%.7,8 More recently published surveys — albeit of selected, rather than consecutive, cases — have demonstrated spontaneous resolution rates of OCT-defined cases of approximately 30%, and the rate of nonprogression has been up to 60%, depending on the anatomic configuration.9,10
A critical consideration is the attribution of symptoms (even more so than decreased VA) to the VMA, which seems to define the subgroup of VMT eyes more saliently for the consideration of therapy.11 Furthermore, studying OCT features seems to allow for stratification of lower prognosis cases for spontaneous release (and pharmacologic treatment for that matter).
Specifically, the associations of VMA with epiretinal membranes12 and broader attachment interfaces13 have both been identified as features that likely lower the rate of spontaneous release of the VMA.
It is this author’s suspicion, based at least on the collation of eyes with good vision that were watched,9 that the cases manifesting what looks like more traction (deviation of deeper retinal layers or even focal subretinal fluid) might paradoxically be the eyes that are more likely to be in the process of releasing.
Certainly, the natural history is incompletely understood, but there do appear to be some signs that might offer the clinician more confidence in observation only, such as cases without progressive or substantial symptoms and good VA or with less extensive ERM and VMA.
SURGICAL TREATMENT FOR VMT
Surgical intervention was the only therapeutic option before ocriplasmin, yet much of the literature was based on what, in retrospect, probably represented the more advanced cases, cases with poorer VA, or cases with more ERM overlap, because they even predated modern OCT imaging. Such case series had results similar to standard ERM series, with approximately 60% regaining at least 2 lines of vision.5,14,15
Case series with OCT-diagnosed cases found similar results, with approximately 50% regaining at least 2 lines of vision but with the findings, variously, that eyes with shorter duration cases,16 less macular distortion,17 or less inner retinal lamellar separation18 generally regained greater amounts of VA.
Also, approximately 5% of operated cases developed postoperative macular hole, presumably attesting to the tenuous nature of the fovea and the firmness of the adhesion.
Still, these cases probably represented the more severe end of the diagnostic spectrum, because the incident VA was at least 20/40 and commonly in the 20/80 to 20/100 range, probably reflecting the more common population with ERMs. It is likely that eyes with broader-based attachments, more severe visual loss, and associated ERMs are better candidates for surgical intervention.
PHARMACOLOGIC TREATMENT: MIVI-TRUST RESULTS
The pivotal study was really two parallel studies reported together, totaling 652 eyes randomized 2:1 or 3:1. This report has been widely presented and is, no doubt, familiar to readers. Briefly summarized, there was a 26.5% rate of spontaneous VMA release with ocriplasmin (compared to 10.1% with a saline injection) by 28 days after a single 125-µg intravitreal injection of ocriplasmin in a 0.1-mL volume.
The subgroup analysis data were where clues were found that might be pertinent for contemporary management. Eyes without ERMs had a roughly four-fold higher rate of VMA release than eyes with ERMs (27.4% vs 8.7%). Eyes with a macular hole had a higher rate of closure (40.6%) than the overall group.
Other data that have been presented (but not in this published report) indicated that the rate of closure with a smaller macular hole (<250 µm) was higher than with medium (250-400 µm) or large (>400 µm) holes (58.3% vs 36.8% vs 0%).
Also possibly pertinent, but not immediately intuitive, were that phakic eyes had almost a three times greater likelihood of VMA release than pseudophakic eyes (34.2% vs 13.4%) and that women had almost twice the chance for spontaneous release (30.3% vs 18.7%).
Generally, the placebo group rates paralleled these same proportions. Also, eyes with poorer incident VA had a higher rate of 3-line improvement, presumably because there was more room for improvement.
There are a couple of other points worth noting. The inclusion criteria allowed patients with VA as good as 20/25. The placebo was a real injection and not a sham injection; somewhat surprisingly, the placebo induced VMA release in a substantial proportion.
Of ocriplasmin-treated eyes underwent subsequent vitrectomy, presumably without unique complications or limitations. Somewhat surprisingly, only 26.6% of the placebo-treated eyes underwent subsequent vitrectomy. This finding might belie a potential bias in that perhaps the patients participating in the trial had an aversion to surgery or possibly had not felt sufficiently symptomatic to consider surgery.
Studies After Ocriplasmin Was Introduced
At least one study has been published19 and several others presented at meetings by investigators not associated with the premarketing studies. Generally, these studies have corroborated the frequency of successful VMA resolution. Those with better success rates have targeted subgroups with better reported results, as summarized above and recommended below.
THE RUB: COMPLICATIONS OF OCRIPLASMIN
The initial study1 reported only two cases of retinal tears with detachment in the ocriplasmin group (0.5%), but the package insert20 implies that one of these cases was in the placebo group. No endophthalmitis or other serious complications were relatable to the medication. Some other retinal tears and detachments were reported, but they seemed to be relatable to subsequent vitrectomy.
The package insert does warn that 2% of patients reported dyschromatopsia, half of whom also had measurable electroretinographic (ERG) changes. Additionally, it warns that a patient (as well as monkeys, rabbits, and mini-pigs) who received a 40% higher dose had a lens subluxation; separately, it warns that monkeys that received a second dose 28 days later had a 100% rate of lens subluxation.
However, other patients have presented postmarketing complications that might relate to ocriplasmin’s cleavage effects on fibronectin and laminin. One woman experienced loss of vision in dim illumination for months; disruption of the ellipsoid layer by OCT imaging and reduced ERG amplitudes were demonstrated.21 Another report with similar, but more severe, findings was published but without follow-up.22 There have been many other anecdotal reports with similar experiences; most common seems to be xanthopsia that is temporary.
RECOMMENDATIONS
Based on the foregoing discussion and drawing heavily on the findings of the pivotal study, as generally corroborated by subsequent series and personal tabulations, the following are the ideal profiles for using ocriplasmin in the presence of VMT.
1. Symptoms relatable to the loss of vision
2. Small macular hole
3. Thin area of VMA
4. No associated ERM
5. Phakic patients
6. Women
Eyes with mild visual symptoms, especially if somewhat chronic and possibly if the OCT features suggest an impending release, are probably best suited for observation, at least initially. Eyes that have larger macular holes or ERMs, pseudophakic eyes, eyes with broader-based VMA, and possibly eyes with more severe or chronic visual loss might be better suited for surgical treatment.
Although there have been reports of toxicity with ocriplasmin, these cases cannot be predicted, they are relatively rare, and they are frequently transient.
However, what is clear from the preclinical studies is that the recommended dosage should never be increased, and a second dose should never be administered, because there is a high rate of zonular dehiscense (and possibly other consequences parallel to the same biochemical action).
FINAL THOUGHTS
A final point is that, although pharmacologic therapy seems less invasive and less expensive, the possibility of complications is still not trivial and is still being defined, and these complications can be devastating. Rudimentary calculations, furthermore, suggest that it is not as cost-effective as vitrectomy, but it is cost-effective compared with other medical interventions.23
Informed patient consent regarding all of these issues will facilitate the targeting of ocriplasmin for the patient most likely to be satisfied and helped. RP
REFERENCES
1. Stalmans P, Benz MS, Gandorfer A, et al; MIVI-TRUST Study Group. Enzymatic vitreolysis with ocriplasmin for vitreomacular traction and macular holes. N Engl J Med. 2012;367:606-615.
2. DeCroos FC, Toth CA, Folgar FA, et al. Characterization of vitreoretinal interface disorders using OCT in the interventional phase 3 trials of ocriplasmin. Invest Ophthalmol Vis Sci. 2012;53:6504-6511.
3. Stalmans P, Duker JS, Kaiser PK, et al. OCT-based interpretation of the vitreomacular interface and indications for pharmacologic vitreolysis. Retina. 2013;33:2003-2011.
4. Sebag J. Anomalous posterior vitreous detachment: a unifying concept in vitreo-retinal disease. Graefe’s Arch Clin Exp Ophthalmol. 2004;242:690-698.
5. Smiddy WE, Michels RG, Glaser BM, de Bustros S. Vitrectomy for macular traction caused by incomplete vitreous separation. Arch Ophthalmol. 1988;106:624-628.
6. Johnson MW. Perifoveal vitreous detachment and its macular complications. Trans Am Ophthalmol Soc. 2005;103:537-567.
7. Hikichi T, Yoshida A, Trempe CL. Course of vitreomacular traction syndrome. Am J Ophthalmol. 1995;119:55-61.
8. Sarup V, Wald KJ, Gross NE, et al. Spontaneous resolution of unilateral vitreomacular traction. Ann Ophthalmol (Skokie). 2006;38:347-349.
9. John VJ, Flynn HW Jr, Smiddy WE, et al. Clinical course of vitreomacular adhesion managed by initial observation. Retina. 2014;34:442-446.
10. Tzu JH, John VJ, Flynn HW Jr, et al. Vitreomacular traction: clinical course when managed by initial observation. Ophthalmic Surg Lasers Imaging. In press.
11. Jackson TL, Nicod E, Simpson A, et al. Symptomatic vitreomacular adhesion. Retina. 2013;33:1503-1511.
12. Koizumi H, Spaide RF, Fisher YL, et al. Three-dimensional evaluation of vitreomacular traction and epiretinal membrane using spectral-domain optical coherence tomography. Am J Ophthalmol. 2008;145:509-517.
13. Theodossiadis GP, Grigoropoulos VG, Theodoropoulou S, Datseris I, Theodossiadis PG. Spontaneous resolution of vitreomacular traction demonstrated by spectral-domain optical coherence tomography. Am J Ophthalmol. 2014;157:842-851.
14. McDonald HR, Johnson RN, Schatz H. Surgical results in the vitreomacular traction syndrome. Ophthalmology. 1994;101:1397-1403.
15. Melberg NS, Williams DF, Balles MW, et al. VItrectomy for vitreomacular traction syndrome with macular detachment. Retina. 1995;15:192-197.
16. Davis RP, Smiddy WE, Flynn HW Jr, Puliafito CA. Surgical management of vitreofoveal traction syndrome: optical coherence tomographic evaluation and clinical outcomes. Ophthalmic Surg Lasers Imaging. 2010;41:1-7.
17. Sonmez K, Capone A, Trese MT, Williams GA. Vitreomacular traction syndrome. Impact of anatomical configuration on anatomical and visual outcomes. Retina. 2008;28:1207-1214.
18. Witkin AJ, Patron ME, Castro LC, et al. Anatomic and visual outcomes of vitrectomy for vitreomacular traction syndrome. Ophthalmic Surg Lasers Imaging. 2010;41:425-431.
19. Kim BR, Schwartz SG, Smiddy WE, et al. Initial outcomes following intravitreal ocriplasmin for treatment of symptomatic vitreomacular adhesion. Ophthalmic Surg Lasers Imaging Retina. 2013;44:334-343.
20. Jetrea [package insert]. Iselin, NJ: ThromboGenics; 2012.
21. Tibbetts MD, Reichel E, Witkin AJ. Vision loss after intravitreal ocriplasmin. Correlation of spectral-domain optical coherence tomography and electroretinography. JAMA Ophthalmol. 2014;132:487-490.
22. Fahim AT, Khan NW, Johnson MW. Acute panretinal structural and functional abnormalities after intravitreous ocriplasmin injection. JAMA Ophthalmol. 2014;132:484-486.
23. Chang JS, Smiddy WE. Cost evaluation of surgical and pharmaceutical options in treatment for vitreomacular adhesions and macular holes. Ophthalmology. 2014;121:1720-1726.








